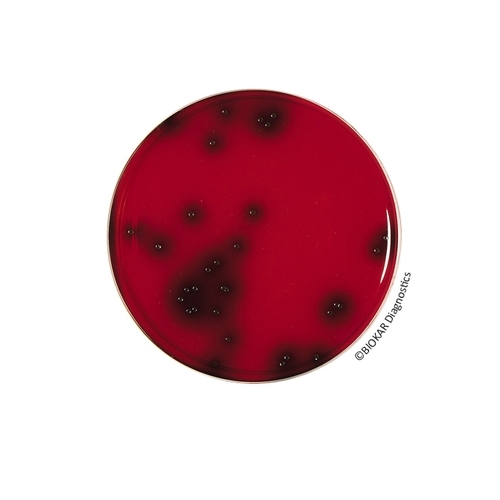
Palcam Agar

Palcam Agar
PALCAM Agar is a selective medium used for the differentiation and isolation of Listeria monocytogenes and other Listeria, from milk and cheese, as well as in other food products, even highly contaminated. The media can be used as a second media of choice in the context of the directives concerning the detection of Listeria monocytogenes in food microbiology. PALCAM agar can also be used as a confirmation test for Listeria spp using the COMPASS® Listeria method.
| Ürün Adı | Palcam Selective Supplement |
| Ürün Kodu | BS00408 |
| Miktar | 10 vials qsp 500 mL |
| Ürün Adı | Palcam Selective Supplement |
| Ürün Kodu | BS04908 |
| Miktar | 8 vials qsp 2,5 L |
| Ürün Adı | Palcam Agar |
| Ürün Kodu | BM02008 |
| Miktar | 20 Petri plates Ø 90 mm |